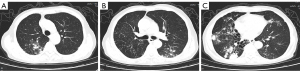
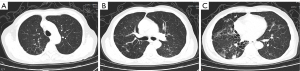
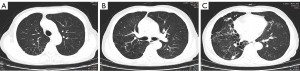

Bedaquiline treatment for a case of nontuberculous mycobacterial pulmonary disease following initial treatment failure
Introduction
Despite an increase in the incidence of lung diseases caused by nontuberculous mycobacteria (NTM) over the past 20 years, effective treatments remain limited (1). Antimicrobial resistance and the side effects of combination medications also contribute to unsatisfactory treatment responses. In this article, we present the case of a patient with NTM pulmonary disease caused by Mycobacterium intracellulare who failed to respond to the initial treatment, but was successfully treated with bedaquiline.
Case presentation
Clinical data
The patient, a 70-year-old male, retiree, with a history of high blood pressure, was admitted to The Second Hospital of Nanjing 6 years ago due to recurrent coughing and sputum production. A chest computed tomography (CT) scan revealed several patches and nodules in both lungs, and bronchiectasis in the right lung. NTM were detected in both sputum specimens using the BACTECTM MGIT 960 culture method. The drug susceptibility test of NTM showed resistance to amikacin and levofloxacin, and intermediate sensitivity to rifampicin and ethambutol. Mycobacterium strains were identified as Mycobacterium intracellulare by quantitative real-time polymerase chain reaction.
After receiving anti-NTM treatments for approximately a year, the patient’s cough and sputum symptoms subsided. However, in May 2021, he experienced an abrupt 500-mL hemoptysis. Following bronchial arteriography and embolization in the emergency room, the hemoptysis improved. As the sputum culture continued to indicate NTM, anti-NTM treatment with ethambutol, rifapentine, and clarithromycin was re-initiated. Subsequently, the patient presented with intermittent coughing accompanied by sputum production and hemoptysis.
Chest CT (Figure 1) on January 23, 2024 revealed a marked progression of lesions in both lungs. Electronic bronchoscopy revealed no obvious abnormalities in the trachea, bronchi, or lobe bronchi. Lavage was performed in the posterior segment of the upper lobe of the right lung and the basal segment of the lower lobe of the right lung. NTM were found in the lavage fluid of the tuberculosis culture. Metagenomic next-generation sequencing of bronchoalveolar lavage fluid revealed Mycobacterium intracellulare, with a count of 5,143 sequences.
The patient was resistant to several anti-NTM medications and had consistently positive tuberculosis cultures due to the progression of the lung lesions. The patient received 0.4 g of bedaquiline (once a day), 0.5 g of azithromycin (once a day), 0.75 g ethambutol (once a day), and 0.4 g of moxifloxacin (once a day); after 2 weeks, the dose of bedaquiline was changed to 0.2 g once a day, three times a week.
Susceptibility tests of bedaquiline and azithromycin indicated that NTM was sensitive to bedaquiline and resistant to azithromycin. As a result, azithromycin was stopped. On April 18, 2024, a chest CT scan (Figure 2) revealed several patchy and nodular hyperdense shadows along the airways in both lungs; these shadows were noticeably reduced compared to those observed in January 2024. A repeat tuberculosis sputum culture was negative. A chest CT scan on June 26, 2024 (Figure 3) showed that the local lesions had improved compared to those observed on April 18, 2024.

All the procedures in this study were performed in accordance with the ethical standards of the institutional and/or national research committee(s), and with the Declaration of Helsinki and its subsequent amendments. Written informed consent was obtained from the patient for the publication of the article and the accompanying images. A copy of the written consent form is available for review by the editorial office of this journal.
Discussion
Resistance to current NTM therapies is now recognized as an issue worldwide. Antibiotics with macrolide properties are the mainstay of treatment for mycobacterium avium complex (MAC). However, a significant proportion of individuals do not respond well to treatment and demonstrate resistance to macrolides. The resistance rates for clarithromycin and azithromycin have been reported to be 14–38% and 10%, respectively (2). Treatment failure in macrolide-resistant NTM pulmonary disease, which has been reported to exceed 70%, can worsen lung damage, reduce quality of life, and ultimately increase mortality (3). Thus, novel medications and treatment approaches for NTM urgently need to be established.
Bedaquiline, a diarylaquiline medication, binds specifically to the adenosine triphosphate (ATP) synthase of mycobacterium tuberculosis, inhibiting the ability of the bacteria to use ATPase to manufacture energy and exhibit anti-tuberculosis effects (4). In the treatment of multidrug-resistant pulmonary tuberculosis, chemotherapy regimens incorporating bedaquiline have shown improved clinical efficacy (5). Consequently, researchers have examined the use of bedaquiline in the treatment of NTM. Bedaquiline has shown potent antimicrobial activity in experimental studies against most standard strains of fast- and slow-growing mycobacterium, with a minimum inhibitory concentration (MIC) of less than 0.008 mg/L for MAC inhibiting 90% of bacterial growth (6). Meybeck et al. effectively treated a human immunodeficiency virus (HIV)-positive patient undergoing kidney transplantation with bedaquiline and moxifloxacin for disseminated Mycobacterium marinis infection (7).
In the present case, treatment with ethambutol, azithromycin, moxifloxacin, and bedaquiline was re-initiated. Consistent with Gil et al.’s findings (8), further in vitro testing revealed susceptibility to bedaquiline (approximate MIC: 0.0625 mg/L), cessation of azithromycin, and resistance to azithromycin (approximate MIC: 8 mg/L). Three months later, a chest CT scan revealed significant improvements in the lesions in both lungs, and the tuberculosis culture in the sputum was negative. The chest CT scan revealed no new lesions and limited improvement in the local lesions after five months of treatment. Patients using bedaquiline should be closely monitored to ensure normal alanine aminotransferase, aspartate transaminase, and normal electrocardiogram findings. The most common adverse reactions in this case were nausea, arthralgia, vomiting, dizziness, and QT interval prolongation.
Bedaquiline treatment produced a notable response in the patient, who had no alternative options due to drug resistance and ongoing lesion advancement. In the future, this case may guide the management of NTM when traditional treatment plans fail due to drug resistance or unfavorable drug interactions.
Acknowledgments
None.
Footnote
Funding: This study was funded by
Conflicts of Interest: All authors have completed the ICMJE uniform disclosure form (available at https://qims.amegroups.com/article/view/10.21037/qims-2024-2596/coif). The authors have no conflicts of interest to declare.
Ethical Statement: The authors are accountable for all aspects of the work in ensuring that questions related to the accuracy or integrity of any part of the work are appropriately investigated and resolved. All procedures performed in this study were in accordance with the ethical standards of the institutional and/or national research committee(s) and with the Helsinki Declaration and its subsequent amendments. Written informed consent was obtained from the patient for publication of the article and accompanying images. A copy of the written consent is available for review by the editorial office of this journal.
Open Access Statement: This is an Open Access article distributed in accordance with the Creative Commons Attribution-NonCommercial-NoDerivs 4.0 International License (CC BY-NC-ND 4.0), which permits the non-commercial replication and distribution of the article with the strict proviso that no changes or edits are made and the original work is properly cited (including links to both the formal publication through the relevant DOI and the license). See: https://creativecommons.org/licenses/by-nc-nd/4.0/.
References
- Dartois V, Dick T. Therapeutic developments for tuberculosis and nontuberculous mycobacterial lung disease. Nat Rev Drug Discov 2024;23:381-403. [Crossref] [PubMed]
- Gu Y, Nie W, Huang H, Yu X. Non-tuberculous mycobacterial disease: progress and advances in the development of novel candidate and repurposed drugs. Front Cell Infect Microbiol 2023;13:1243457. [Crossref] [PubMed]
- van der Laan R, Snabilié A, Obradovic M. Meeting the challenges of NTM-PD from the perspective of the organism and the disease process: innovations in drug development and delivery. Respir Res 2022;23:376. [Crossref] [PubMed]
- Sarathy JP, Gruber G, Dick T. Re-Understanding the Mechanisms of Action of the Anti-Mycobacterial Drug Bedaquiline. Antibiotics (Basel) 2019;8:261. [Crossref] [PubMed]
- Gao M, Gao J, Xie L, Wu G, Chen W, Chen Y, et al. Early outcome and safety of bedaquiline-containing regimens for treatment of MDR- and XDR-TB in China: a multicentre study. Clin Microbiol Infect 2021;27:597-602. [Crossref] [PubMed]
- Yu X, Gao X, Li C, Luo J, Wen S, Zhang T, Ma Y, Dong L, Wang F, Huang H. In Vitro Activities of Bedaquiline and Delamanid against Nontuberculous Mycobacteria Isolated in Beijing, China. Antimicrob Agents Chemother 2019;63:e00031-19. [Crossref] [PubMed]
- Meybeck A, Tetart M, Baclet V, Alcaraz I, Blondiaux N, Peytavin G, Veyziris N, Robineau O, Senneville E. A disseminated Mycobacterium marinum infection in a renal transplant HIV-infected patient successfully treated with a bedaquiline-containing antimycobacterial treatment: A case report. Int J Infect Dis 2021;107:176-8. [Crossref] [PubMed]
- Gil E, Sweeney N, Barrett V, Morris-Jones S, Miller RF, Johnston VJ, Brown M. Bedaquiline as Treatment for Disseminated Nontuberculous Mycobacteria Infection in 2 Patients Co-Infected with HIV. Emerg Infect Dis 2021;27:944-8. [Crossref] [PubMed]


